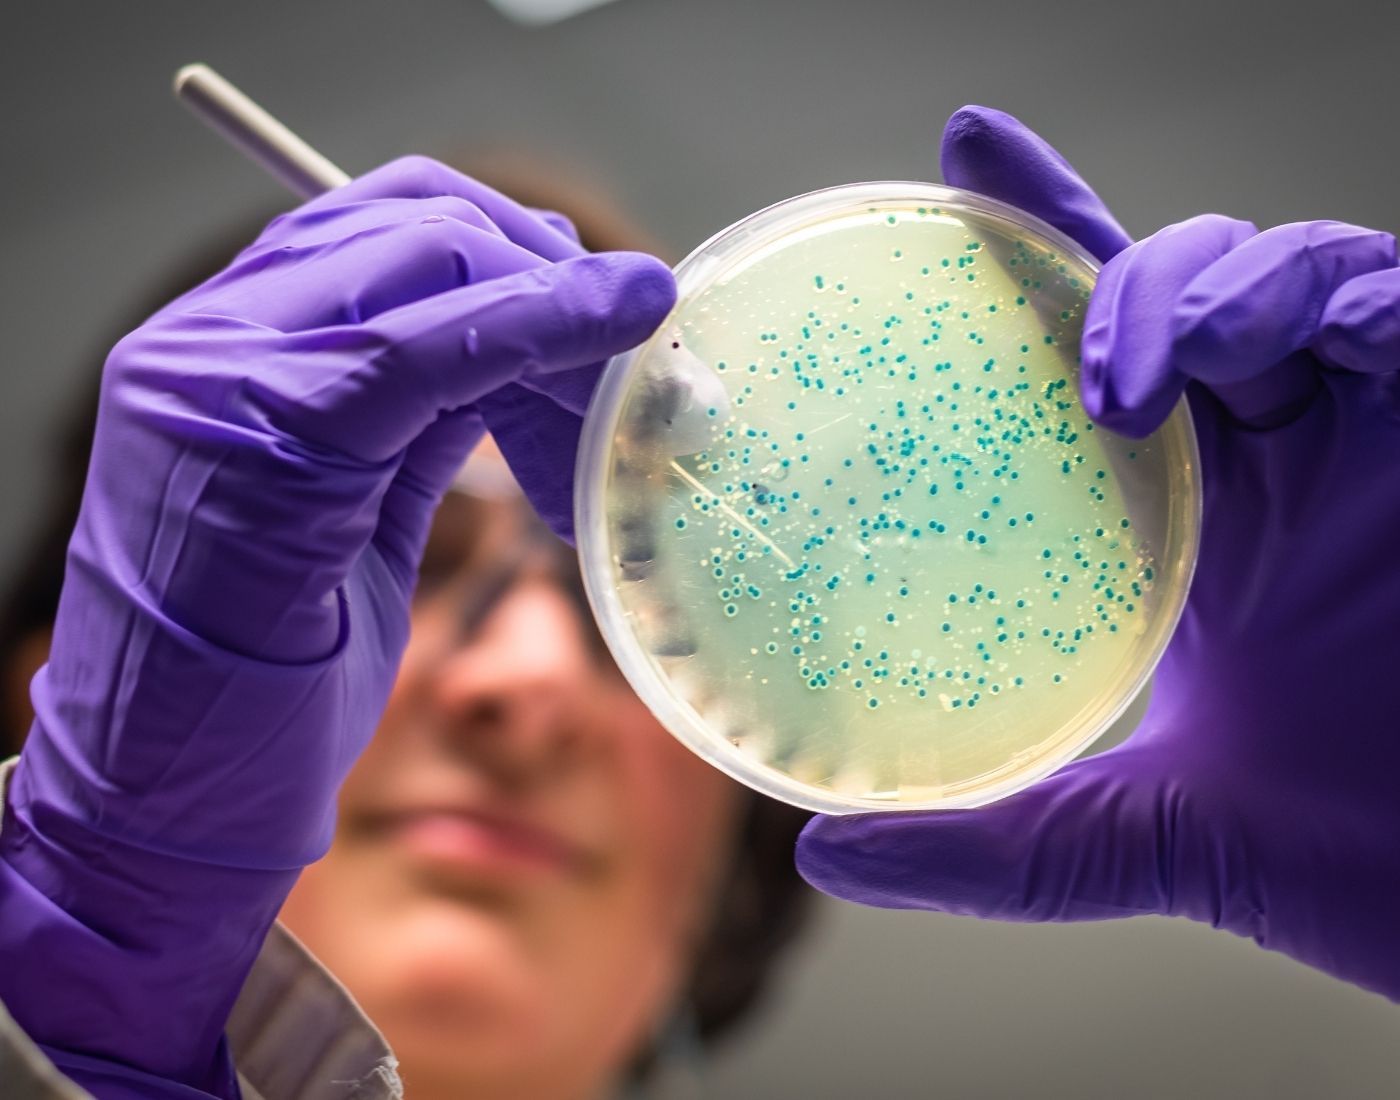
Researcher looking at a petri dish

We ensure high levels of governance to ensure our science is:
- Strategic - focused on our priorities and shaped by the interests of Scottish consumers
- Robust - strengthened through peer review and expert scrutiny
- Independent - free from undue political or industry influence, with clear separation for risk assessment and risk management decision-making
- Transparent - open about how we use evidence, including uncertainties, and committed to publishing our findings
- Innovative - driving new scientific understanding to support public health and Scotland’s food system
- Forward-looking - monitoring emerging science and identifying future evidence needs through horizon scanning